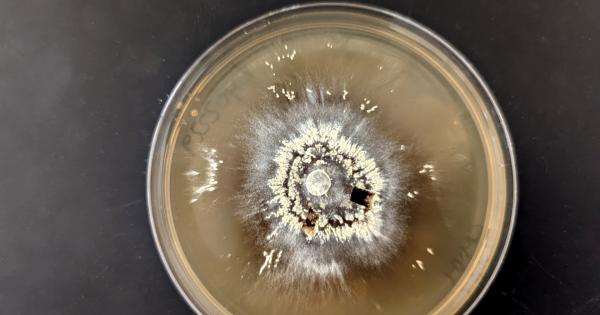
Мегапожарите са изключително опустошителни но тези микроби процъфтяват в тяхЗнаем

... учениците ще разговарят известни лица - Папи Ханс, Георги Блажев, Филип Буков, както и представители на Асоциация "Будителките“, с които заедно се реализира този проект.
Тези Изключително - Новини
Столична община въвежда Зелен билет за пътуване в градския транспорт
...... у нас е бил "изключително замърсен". Европейския индекс за качество на въздуха отчита силно замърсен въздух и в Перник, Пловдив, Стара Загора, Велико Търново и Русе.
Столична община въвежда Зелен билет за пътуване в градския транспорт
...... у нас е бил "изключително замърсен". Европейския индекс за качество на въздуха отчита силно замърсен въздух и в Перник, Пловдив, Стара Загора, Велико Търново и Русе.
Малко хора знаят какви усилия са положили САЩ за да
...... това заключение след анализ на маршрутите на полетите на вражеските разузнавателни дронове и информация от очевидци. Той добави, че не става въпрос за фронтовата зона.
Малко хора знаят какви усилия са положили САЩ за да
...... това заключение след анализ на маршрутите на полетите на вражеските разузнавателни дронове и информация от очевидци. Той добави, че не става въпрос за фронтовата зона.
Ръководят се от мотото Или всичко или нищо и имат
...... могат да виждат бъдещето или да контролират силата на мисълта си. По-добре е да не вредите на Скорпионите, защото, ако решат, ще ви съсипят живота! /jenata.blitz.bg
Докато баскетболната общественост постепенно насочва вниманието си към Финалната четворка
...... и Жалгирис. Сега, Байерн създаде страхотна традиция с цялата си организация. Това са марките, които правят европейския баскетбол по-добър", заяви спортният директор на Анадолу Ефес.
Супите са изключително здравословни ястия за нашия организъм Въпреки че
...... достатъчно количество фибри, витамини от група В и магнезий, пише zdrave.to. Тези вещества имат положителен ефект върху работата на сърцето, кръвоносните съдове и нервната система.
Супите са изключително здравословни ястия за нашия организъм Въпреки че
...... достатъчно количество фибри, витамини от група В и магнезий, пише zdrave.to. Тези вещества имат положителен ефект върху работата на сърцето, кръвоносните съдове и нервната система.
Избирателната активност е много по висока отколкото се очакваше Има такъв
...... още ИТН стои устойчиво, за което сме им благодарни. Ще изчакаме да видим какви ще бъдат финалните резултати и всичко по реда си", каза Йорданов.
Стремежът към оптимално здраве и жизненост при мъжете най често включва
...... простатата и могат да намалят симптомите на доброкачествена хиперплазия на простатата. Освен това копривата съдържа минерали като магнезий и желязо, които подобряват енергийния метаболизъм и физическата издръжливост.
Бившият лидер на БСП Корнелия Нинова даде първата си пресконференция след като
...... може да мине тихомълком и никой да не му обърне внимание, а е хубаво нещата да се изпипват в детайли, защото засягат много хора", коментира още тя.
Тези избори са изключително ключови Не всичко зависи от контролиращите
...... и може да се различава от тази на SafeNews Тези избори са изключително ключови Още новини четете в: Коментари За още актуални новини: Последвайте ни в Google News
Тези деца са изключително талантливи и вече успели на големи
...... Монте Карло, които завоюваха "Златен клоун" и договор с Цирк дю Солей. "Българската публика ще може да види коронния номер на знаменития Цирк дю Солей".
Тези европейски избори са изключително важни бих казал дори съдбовни
...... политика. Не е на всяка цена, но не го изключвам", заяви Станишев.Последвайте ни във и Вече може да ни гледате и в Намерете ни в
Дървесните ядки като лешниците са един от най богатите на полезни
...... форма на диабет и хронични заболявания на черния дроб трябва да изключат лешниците от менюто си.Дневната доза не трябва да превишава 30-50 грама (за възрастни).
Без значение дали изборите през юни ще са 2 в
...... пречистване, да назначим хора, които обещават неща и ги изпълняват. Това зависи от нашата памет, каква отговорност търсим и колко сме склонни да им прощаваме."
Изборите през юни без значение дали ще са 2 в
...... пречистване, да назначим хора, които обещават неща и ги изпълняват. Това зависи от нашата памет, каква отговорност търсим и колко сме склонни да им прощаваме."
Joe Manganiello е играл върколак стриптизьор и адвокат На Острова на
...... пикантни новини за знаменитости до завладяващи истории за човешки интерес.Deal or No Deal Island е с премиера в понеделник от 21:30 ч. ET по NBC.
Британската кралица Камила описа крал Чарлз като изключително добре при
...... ви благодаря , също и за милите съобщения за подкрепа за Катрин и за баща ми, особено през последните дни.„Това означава много за всички нас.“
Камила успя да се усмихне когато пристигна на музикалната вечер
...... за да се събере отново с трите си деца, но 42-г. -старата бъдеща кралица не се очаква да се върне към официални задължения преди Великден.
За много хора Новата година е символично начало и шанс
...... разцъфтят отново. Това е най-доброто време да се отворите към друг човек, да се доверите, но също така ясно да определите границите и очакванията си.
Какво мислите за капките за очи Привидно безобидната бутилчица се
...... който се продава незаконно в САЩ. Както и всичко със сребърен сулфат или аргентум, защото те могат да променят трайно белия цвят на очите ви.
Това заяви в предаването Пресечна точка министърът на околната среда
...... работи, колко организирано се работи. Удивително е също, звучи малко като самохвалство, но как всички правителствени институции се задействаха с изключително добра координация", подчерта министърът.
Контраофанзивата започна от около 2 месеца и се развива сравнително
...... тактика от Европа и САЩ, но това е трудно, сега сме преминали към етап на изтощение, за да видим коя ще поддаде първа“, смята експертът.
Надявам се това нещо да го решим в парламента Вчера
...... този начин. Щом не искат да го наричат с възприетата дума “коалицията” от 30 години, нека го наричат с нови думи, каза още лидерът на ГЕРБ.
Това заяви пред ФрогНюз Методи Андреев Ето и цялото интервю Господин Андреев
...... премахнат и така наречения “инженеринг” като основна форма за строителство на големите инфраструктурни проекти. Това е корупционната форма, чрез която се източваха най-големите средства. Джесика Вълчева
Но тези които днес отказват да преговарят с правителството са
...... Но нека излязат резултатите, и пак ще си говорим. Политологът проф. д-р Татяна Дронзина, дългогодишен преподавател в катедрата по политология в СУ „Св. Климент Охридски“, Facebook
Това заяви пред ФрогНюз Методи Андреев Ето и цялото интервю Господин Андреев
...... премахнат и така наречения “инженеринг” като основна форма за строителство на големите инфраструктурни проекти. Това е корупционната форма, чрез която се източваха най-големите средства. Джесика Вълчева
Очаква се лидерите на четири от петте държави които имат
...... се възприема от много държави като липса на ангажимент към ООН, а това не е добре", казва Питър Йео, старши служител във Фондацията на ООН.
Можем да овладеем ситуацията ако обясним ясно за какво става
...... ние сме длъжници към развитието на зелената енергетика в тези райони. Съдбата на въглищните централи е очевидна за мен и за много хора, заяви екоминистърът.
Премиерът показа че изобщо не познава как функционира земеделският бранш
...... към земеделската дама: "Участието ви днес обяснява защо не ходите и няма да отидете при премиера на разговори и защо той използва термина за терористите".
Това че няма опонент на ГЕРБ за нас не е
...... бюджетът е изключително важен инструмент за управлението на града. Много бързо ние ще подготвим, включително по нов модел, бюджетът за 2024 г., заяви Борис Бонев.
Това заяви историкът проф Веселин Янчев по време на представянето
...... да има покаяние и прошка. Септемврийското въстание беше едно събитие, наложено отвън. По решение на българите може да се направи една преоценка и преосмисляне", подчерта тя.
Това заяви пред Българското национално радио евродепутатът Радан Кънев Коментарът му
...... ще се вземе, след като минат изборите в Полша, която има портфолиото на земеделския комисар. Парламентарният вот в Полша ще се проведе на 15 октомври.
Става въпрос за обявената на 19 юни 2023 г обществена
...... Копривщица (1934).** Александър Божинов е художник, публицист и писател, един от авторитетите в областта на карикатурата (на чиято е смятан и за основоположник) и илюстрацията.
ChatGPT е доста нашумяла тема напоследък тъй като започна да
...... които имат голямо бъдеще. Имайте предвид обаче, че крипто индустрията разчита и на социалните нагласи, затова и нищо не може да бъде предсказано на 100%.
Есента чука на вратата а с нея идват все прекрасни
...... Риби трябва да очакват попълнение в семейството или пристигането на роднини, които ще решат много проблеми и ще помогнат финансово. Виж още: Изображение: iStock photos
Новата година вече чука на вратата а звездите са категорични
...... Става въпрос и за лични взаимоотношения, и за професионални такива. Годината е подходяща за нови начинания като професионални или езикови курсове например. Източник thumbnail: Deagreez/andriano_cz/iStock
За съжаление изневярата се случва по често отколкото ни се иска
...... видят, че няма накъде да мърдат, ще бъдат искрени. Но бъдете сигурни: ако Везните се чувстват пълноценно, никога няма да ви изневерят. Източник thumbnail: Deagreez/nevarpp/iStock
Различните знаци на награждават хората с определен набор от качества
...... който да им подхожда идеално, тези пет зодиакални знака вероятно ще останат самотни в живота и последните си дни ще прекарат сами! Водолей… Цялата статия
Хирургията често е само временно решение защото след известно време
...... със суха кърпа. Използвайте върха на пръстите си, за да масажирате болезнената става с тинктурата. След това обуйте памучни чорапи и си починете за известно време.
Жени Живкова от време на време се появява в публичното
...... се градеше и имаше работа за всички. „Не трябва да забравяме, че ние сме наследници на градежа“, заключи шефът на историческия музей в Правец. Инфо: Нюзбг
Нарушаването на реалността и намирането на хумор в обичайните неща
...... сексуалността, формите на тялото или нещо толкова просто като банан. Разгледайте интересните фотографии на Амбра. те са още едно доказателство за безграничните възможности на човешкия мозък.
Жените от тези зодии ще бъдат най добрият избор за мъжете
...... а честите разходки ще помогнат да отслабне. Нейната енергия и оптимизъм ще станат заразни. Мъжете ще няма да имат нетърпение да се срещнат с нея.
Мегапожарите са изключително опустошителни но тези микроби процъфтяват в тяхЗнаем
...... Гласман – За да могат нашите възстановителни усилия да бъдат успешни, трябва да научим повече за тези микроби.“ Изследването е публикувано в Molecular Ecology. Източник: Science Alert
Определени качества вървят ръка за ръка с други качества Например
...... общуването с околните. Тъй като са критични и придирчиви, хората често смятат Девите за дребнави и ограничени и им лепват етикета „кон с капаци“.
Рекордьорът по победи за Купа Дейвис Димитър Кузманов записа успех
...... за успеха на "Купа Дейвис"- Какво са следващите турнири на които ще участваш?- В петък заминавам за Индия за три последователни турнири от веригата "Чалънджър".





,fit(968:545)&15:07:32)










:max_bytes(150000):strip_icc():focal(719x89:721x91)/joe-manganiello-020623-1-a3dfbc68aa60483293b06f21993ea214.jpg)

&16:35:50)